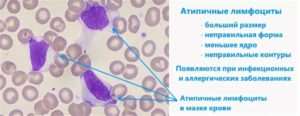
Атипичные лимфоциты в крови
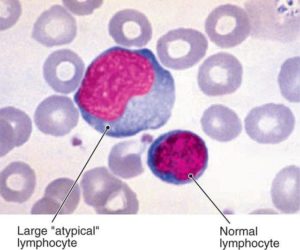
Атипичные лимфоциты в крови

Атипичные лимфоциты: норма и причины появления атипичныех лимфоцитов в анализе крови
Не секрет, что за борьбу с болезнями в нашем организме отвечают крохотные тельца, называемые антителами. За их выработку отвечает красный костный мозг — орган кроветворения, в недрах которого созревают новенькие иммунные клетки: лимфоциты, нейтрофилы, базофилы, эозинофилы и моноциты.
Главнейшим агентом иммунного ответа являются лимфоциты — их численность в крови преобладает над всеми остальными, именно с помощью них организм ведёт основную борьбу с инфекцией. Большинство лимфоцитов имеет правильную круглую форму и чёткие контуры, однако есть клетки, параметры которых немного отличаются от «оригинала». Такие клетки учёные называют атипичными.
Атипичные или реактивные лимфоциты — это особые иммунные тела, появляющиеся при аллергических реакциях, инфекционных и других заболеваниях. Неправильная форма и размер клеток обусловлены воздействием патогенных микроорганизмов, полностью меняющих их структуру. В норме атипичные иммунные тела не должны появляться вообще, а их наличие может указывать на развитие различных заболеваний.
В этой статье мы расскажем вам, что делать, если в вашем анализе крови обнаружены атипичные лимфоциты, поведаем о причинах, которые могли спровоцировать их рост.
В чём проявляется атипичность лимфоцитов?
Как известно, лимфоциты участвуют в процессах иммунного ответа — то есть, одни из первых бросаются на борьбу с опасными микроорганизмами. В результате этой борьбы они могут приобретать следующие параметры:
- Нестандартный внешний вид
Обычно лимфоцит имеет круглую форму и ровные границы. Атипичные лимфоциты отличаются рваными контурами и неправильной многоугольной структурой.
В нормальном состоянии размер лимфоцита не превышает 12 мкм. Увеличение этого показателя говорит о его атипичности.
Воздействие патогенных организмов распространяется также и на ядро клетки — если посмотреть на неправильный агранулоцит через микроскоп, можно обнаружить, что оно вытянуто, удлинено, испещрено продолговатыми трещинками.
Атипичные лимфоциты также имеют более яркий окрас, при добавлении в анализируемую кровь красителя гематоксилина — это также один из способов выявления необычных клеток.
А вы знали, что черты характера человека влияют на его уровень сопротивляемости болезням? Есть исследование, подтверждающее, что активные и уверенные в себе люди вырабатывают большее количество клеток иммунного ответа, что и помогает им бороться с болезнями. Таким образом, оптимистичный и положительно настроенный человек имеет меньше поводов для беспокойства о своём здоровье.
Причины появления атипичных лимфоцитов
Многие люди, напуганные различными статьями в интернете и медицинских справочниках, уже на рефлекторном уровне начинают паниковать при виде слов «атипичный», «неправильный» и «мутагенный», ассоциируя их с онкологическими заболеваниями. Не спорю, повышенное число лимфоцитов, как и появление атипичных лимфоцитов, может являться косвенным симптомом рака, но это лишь одна из возможных причин, причём не самая распространённая.
Гораздо чаще к усилению выработки лимфоцитов приводит какая-либо инфекция или же аллергическая реакция. Такое явление называют лимфоцитозом. Медики различают три разновидности данного заболевания: реактивный, постинфекционный и злокачественный. Первые два связаны с ослаблением функций организма в результате инфекции, третий — с наличием опухолевого процесса в организме.
Лимфоцитоз неизбежно ведёт к образованию неправильных лимфоцитов, а точнее, он является одним из факторов, сопутствующих данной патологии. Причин у неё может быть несколько:
- Приём определённого круга лекарственных препаратов (к примеру, иммунных сывороток органического происхождения);
- Инфекционные заболевания: пневмония, ветрянка, гепатит и т.д.
- Бруцеллёз — заболевание, поражающее домашних животных. Попадая в организм человека через продукты питания, может вызывать нарушение в работе различных систем, в том числе и иммунной;
- Токсоплазмоз — заболевание без явной клинической картины, поражающее, однако, иммунные клетки организма и приводящее к возникновению реактивных лимфоцитов;
- Лимфолейкоз — злокачественное поражение лимфатических узлов, характеризующееся накоплением в них раковых клеток;
- Коклюш — заболевание дыхательных путей, сопровождаемое судорожным кашлем. Чаще всего встречается у детей;
- Сывороточная болезнь — аллергия на препараты животного происхождения;
- Сифилис на некоторых стадиях.
Уровень агранулоцитов в крови определяется общим анализом крови (на тромбоциты, эритроциты и лейкоциты). Сдаётся такой анализ обычно с утра и на голодный желудок.

Стоит отметить, что в крови взрослого человека можно обнаружить атипичные лимфоциты и при отсутствии патологического процесса в организме, поэтому так важно проконсультироваться с врачом насчёт результатов вашего анализа — именно он первым заметит неладное и посоветует, что делать в сложившейся ситуации.
Ещё одним немаловажным фактором развития атипичных агранулоцитов является аллергия. Врачи по всему миру твердят о том, что аллергические реакции станут одной из главных проблем, преследующих городских жителей в XXI веке.
Дело в том, что в условиях экологических катаклизмов и загрязнённости воздуха, иммунная система человека начинает работать неправильно, «сбоить».
Официальная статистика показывает, что уже сейчас число болеющих аллергией детей составляет 15%!
Норма атипичных лимфоцитов и лечение
В организме здорового человека может содержаться до 6 % атипичных лимфоцитов, большая часть из них консолидируется в кровеносной системе. Стоит встревожиться, если этот уровень превышает 7-10%, именно на это и необходимо указать своему врачу.
Лечение атипичных лимфоцитов, естественно, заключается в выявлении первопричины, а до тех пор не стоит прибегать к каким-то серьёзным мерам.
Чаще всего врачи назначают:
- Витаминно-минеральную терапию, укрепляющую иммунитет.
- Если заболевание имеет вирусную природу, соответственно назначаются антибиотики и противовирусные препараты.
- Антигистаминные и противоаллергические лекарства, если образование атипичных лимфоцитов спровоцировано аллергией.
Не стоит забывать также и о правильном питании, здоровом образе жизни и других мероприятиях, направленных на укрепление организма.
Резюмируя:
Лимфоциты — это группа иммунных клеток крови, подвид лейкоцитов, участвующая в борьбе организма с инородными телами и вирусами.
Когда иммунная клетка сталкивается с серьёзной проблемой, его структура, размер и цвет могут меняться, и тогда можно говорить о развитии его атипичности.
Норма атипичных лимфоцитов в крови человека составляет 6%, всё, что выше — свидетельствует о негативных изменениях в работе организма. Эти нарушения, в свою очередь, могут быть вызваны как вирусами, так и опухолевыми процессами, требующими немедленного лечения.
На этом всё, следите за состоянием своего организма, ведите здоровый образ жизни и не пускайте на самотёк имеющиеся проблемы, именно в этом и заключается секрет крепкого здоровья. Удачи!
Атипичные лимфоциты: норма в анализе крови у взрослых и детей, причины повышения — Опухоли нет
Противостоять болезням организму помогают антитела. Их выработка происходит в костном мозге. Здесь идёт созревание лимфоцитов, нейтрофилов, базофилов, эозинофилов, моноцитов. Больше всего образуется лимфоцитов – главных борцов иммунной системы, которые занимаются защитой организма.
Наряду с ними существуют клетки с особыми параметрами, функциями. Атипичные лимфоциты – это разновидность иммунных тел. Причиной их появления становятся аллергические реакции, инфекции. Воздействие патогенных организмов меняет их структуру, форму. При нормальном состоянии человека они отсутствуют.
Разного рода заболевания провоцируют их появление.
Особенности
Атипичный или реактивный лимфоцит имеет особенности. Его отличают:
- Форма неправильного многоугольника с рваными краями. Для здорового лейкоцита характерны ровные границы, округлость.
- Увеличение размера. Самыми крупными лейкоцитами являются макрофаги. Их размер достигает 12 мкм. Для лимфоцитов характерен небольшой размер. Они увеличиваются под влиянием вирусов и достигают 30 мкм.
- Клеточное ядро вытягивается, становится продолговатым. При исследовании под микроскопом видны трещины.
- Окрашивание в яркий цвет при анализе с использованием гематоксилина и эозина. Клетки меняют окрас на синий, иногда на тёмно-серый. Цвет ядра становится фиолетовым.
Чтобы выявить присутствие аномальных клеток, анализируют состав крови, так как она содержит большое число иммунных тел. Ткани организма аккумулируют их в меньшем количестве.
Разновидности
Структура клетки меняется под воздействием микроорганизмов. Как результат, полностью меняются её функции и параметры.
Дегенеративные
Период длительной интоксикации приводит к образованию дегенеративных клеток, которые не способны делиться и функционировать из-за скопившихся токсинов. Их размер уменьшается либо увеличивается. Виновниками изменений называют дистрофию печени, сепсис, абсцесс.
Клетки Дауни
Размер атипичных мононуклеаров больше, чем здоровых лимфоцитов. Для них характерно наличие моноцитарного ядра. Лимфомоноциты являются показателем наличия вирусной инфекции. Чаще всего это герпес либо мононуклеоз. Выздоровление приводит к нормализации состава крови.
В крови у детей атипичные мононуклеары присутствуют в количестве не более 1%. Показатели могут быть повышены из-за недавно перенесённых болезней или прививки. У взрослых их также обнаруживают.
Появление таких клеток связывают с ростом вероятности заражения герпесом или проявлением аллергии.
Клетки-тени Боткина-Клейна-Гумпрехта
Это понятие включает разрушенные лимфоидные клетки, полученные при подготовке исследуемого материала к анализу. Это значит, что кровяные тельца подвержены быстрому разрушению. Из-за сложности обнаружения они названы тенями. Характерно для хронического лимфолейкоза.
Клетки Ридера
Обнаружение почкообразных клеток с ядрами, имеющими зазубренный контур, сигнализирует о серьёзных заболеваниях. Чаще всего человек болен лейкемией, пернициозной анемией, тяжёлыми инфекциями.
Что вызывает появление
При обследовании обнаруживают атипичные лимфоциты в анализе крови даже при отсутствии жалоб.
При развитии болезни их число растёт, попутно появляются новые атипичные клетки, главными виновниками возникновения которых становятся инфекции вирусного происхождения, аллергия. Попадание микробов внутрь организма провоцирует защитную реакцию иммунной системы.
Начинается выработка антител для борьбы с возбудителем заболевания. При сниженной иммунной защите созревание может не произойти, клетка видоизменяется, приобретает иные качества.
Превышение нормы содержания в крови лимфоцитов, а также образование атипичных клеток может возникать при наличии рака. Наряду с ним существуют другие причины. Самая частая – инфекции, а также аллергия, от которой страдают жители мегаполисов. Приумножение числа лимфоцитов ведёт к лимфоцитозу.
Выявление клеток с нетипичными свойствами ассоциируется с опасными болезнями. Известны четыре основных группы факторов, влияющих на их возникновение:
- Присутствие в организме инфекций, вызванных вирусами, бактериями.
- Последствия интоксикации.
- Радиационное воздействие.
- Онкологические заболевания, наличие генетических патологий.
Нетипичные лимфоцитарные клетки образуются, если человек болен:
- Бруцеллёзом – заболеванием домашних животных, передающимся людям. Недуг протекает с поражением нервной системы, сердца, сосудов, костей, суставов.
- Лимфолейкозом – онкологией, при которой злокачественные клетки поражают ткани лимфы.
- Сифилисом – венерическим заболеванием с поражением кожных, слизистых покровов. Болезнь ухудшает состояние костной ткани, осложняет работу органов и систем.
- Токсоплазмозом – бессимптомной инфекцией, вызванной токсоплазмами. Источником заражения становятся кошки.
Лекарства и сыворотки, имеющие животное происхождение, также способствуют формированию реактивных лимфоцитов. У ребёнка этот процесс вызывают менингококковая инфекция, коклюш, корь, ряд других заболеваний.
Диагностика выявляет присутствие атипичных лимфоцитов у здоровых людей. Даже если взрослый человек не жалуется на проявления болезней, ему рекомендуют обратиться за консультацией к гематологу.
Реактивные лимфоциты в детском возрасте
Обозначение нормы состава крови детей и взрослых отличается. В организме здорового ребёнка отсутствуют атипичные лимфоциты. Часто причиной их появления становится мононуклеоз. При этой болезни нарушается целостность лейкоцитов, меняется состав их ядра. В результате иммунитет ослабевает, ребёнок заражается инфекциями.
Причинами лимфоцитоза у детей считают:
- вирусный гепатит;
- приём лекарств, таких как Тетрациклин;
- дефицит витаминов и минералов;
- проблемы пищеварительных органов;
- ветрянку, корь, скарлатину.
Ускорить выздоровление, избежать осложнений помогает ранняя диагностика. Выявить наличие проблемы способен анализ крови. Известный педиатр Комаровский рекомендует проводить такое исследование минимум один раз в год. Это позволит иметь сравнительные данные о составе крови, когда ребёнок здоров, а также во время болезни.
Симптомы
Атипичные лимфоциты никак не проявляются. Симптоматика возникает, когда болезнь поражает органы. Родители отмечают у детей:
- повышение температуры;
- появление сонливости, слабости;
- распространение инфекции на органы дыхания.
В ряде случаев появляются высыпания, кожа начинает зудеть. Отсутствие лечения ухудшает состояние. Требуется получить медицинскую помощь.
Лечение
Для нормализации состояния врачи проводят комплексную терапию:
- Лимфоцитарными препаратами снижают уровень лимфоцитов.
- Противовирусными, противовоспалительными средствами, антибиотиками борются с вирусами, инфекциями.
- Подбирают диету. Рекомендуют питание с высоким содержанием витаминов, микроэлементов. Ограничивают потребление жиров, соли.
- С онкологическими заболеваниями борются проведением курса химиотерапии.
Допустимые значения
Присутствие атипичных лимфоцитов допустимо у совершенно здорового человека, их норма – менее 6%. Повышенные показатели говорят о развитии патологии, необходимости начать лечение. В такой ситуации врач проводит диагностику и обследование. Для выбора лечения выясняют первопричину недуга.

Часто рекомендуют употреблять витамины, минералы, чтобы укрепить иммунитет. Заболевание вирусного характера лечат противовирусными препаратами. Аллергию устраняют противогистаминными, антиаллергенными средствами. Врачи советуют придерживаться диеты, исключить вредные привычки.
Клетки с атипичными свойствами в организме сигнализируют о проникновении вируса, развитии патологии. Обращение в поликлинику поможет выявить причину и устранить её.
Атипичные мононуклеары (вироциты) в крови у взрослых и детей
Атипичные мононуклеары или вироциты — разновидность лимфоцитов, клеточная структура которых имеет сходство с моноцитами. Они имеют одноядерное строение. Появление в крови может указывать на развитие инфекционного вирусного заболевания. Если при этом наблюдается изменение количественного показателя крови, это указывает на прогресс вируса в организме.
Важно! В данном случае проводится дополнительное обследование, так как атипичные мононуклеары характерны для инфекционного мононуклеоза.
Факторы появления вироцитов в крови
Причиной возникновения мононуклеарных клеток в крови является попадание в организм человека вирусной инфекции.
Важно! Когда человек полностью здоров, атипичные мононуклеары в крови составляют минимальный процент или вовсе отсутствуют.
Когда уровень вироцитов в анализе крови составляет более 10%, данное состояние может спровоцировать:
- инфекционное, вирусное заболевание в острой форме (в частности, мононуклеоз, ветряная оспа);
- вакцинация (как ответная реакция организма на введение фрагментов вируса).
Примечание: мононуклеары атипичные в начале развития патологии увеличивают свою численность вместе с другими видами клеток (палочкоядерными нейтрофилами), в то время как концентрация сегментоядерных клеток уменьшается.
Атипичные мононуклеары в крови у ребенка, как правило, вызваны вирусом Эпштейна-Барра, поражающим верхние дыхательные пути, шейные лимфоузлы.
Высокая концентрация вирусных клеток наблюдается на поверхности глотки, в тканях печени, селезенки, лимфоузлах.
Поэтому после инкубационного периода, длящегося от 5 до 15 суток, нередко отмечается увеличение размеров селезенки и печени.
Инфекционный мононуклеоз причисляют к вирусам группы герпесов 4 типа.
Симптомы, характерные при увеличении уровня мононуклеарных клеток у детей
Дети первого года жизни наименее подвержены заболеванию Эпштейна-Барра. Объясняется это наличием врожденного пассивного иммунитета к данному вирусу.
Однако у детей в 7–10 лет отмечается снижение защитных функций организма, в связи с чем у пациентов данной возрастной группы нередко обнаруживаются атипичные мононуклеары в общем анализе крови.
В этом возрасте зарегистрировано наибольшее число заболеваний инфекционным мононуклеозом.
Симптомы, которые являются признаком повышения вироцитов в крови у ребенка:
- гипертермия (высокая температура тела — 380 и выше);
- усиленное потоотделение;
- уплотнение, увеличение лимфатических узлов (в шейной области);
- налет белого цвета на миндалинах;
- набухание небных миндалин;
- количественное изменение химического состава крови (изменение лимфоцитарной формулы);
- увеличение размеров печени, селезенки.
Вас также могут заинтересовать нормы содержания лимфоцитов в крови у женщин и прочитать о них можно в следующей статье на нашем портале.
Примечание: согласно статистическим данным более подвержены инфекционному мононуклеозу мальчики в возрасте до 10 лет.
Признаками инфицирования может быть кожная сыпь, имеющая петихиальный характер и различную локацию.
Признаки повышения атипичных мононуклеаров у взрослых
Клинические проявления начальной стадии патологии у взрослых:
- упадок сил;
- тошнота;
- катаральные явления — отечность носоглотки, затрудненное носовое дыхание, сиплость голоса, прочее;
- гнойные образования на задней стенке гортани;
- озноб, резкое повышение температуры;
- ноющая боль в суставах, мышцах.
Основными проявлениями патологий, при которых возрастает численность атипичных мононуклеаров, являются:
- проявления интоксикации (тошнота, потоотделение, озноб, прочее);
- набухание лимфоузлов;
- одновременно увеличение размеров селезенки, печени;
- мигрень;
- усиление боли в суставах, мышцах;
- появление симптомов ангины (гиперемии слизистой неба, желтый налет рыхлой структуры на небных миндалинах, боль в горле).
Примечание: может наблюдаться отечность лица по причине нарушенного лимфооттока. Лимфоузлы могут увеличиваться до 5 см в диаметре. При пальпации болезненные ощущения либо незначительны, либо вовсе отсутствуют.
В активной фазе мононуклеоза увеличивается печень и селезенка. При этом нередко возникает желтушный синдром со следующими проявлениями:
- тошнота, доходящая до рвоты;
- снижение, отсутствие аппетита;
- изменение цвета мочи (потемнение, мутность);
- тянущая боль, чувство распирания в подреберье с правой стороны;
- желтый оттенок кожных покровов, глазного белка;
- расстройство стула (запор, диарея).
Спустя 10-12 дней после появления первых симптомов по телу может распространиться пятнисто-папулезная сыпь неопределенной локализации, которая не вызывает зуда.
Болезни, при которых возрастает уровень атипичных клеток
Атипичные мононуклеары в общем анализе крови являются признаком инфекции в организме. Точный диагноз можно установить исходя из следующих критериев форменных клеток:
- изменение структуры и формы;
- увеличение количества;
- изменение процентного соотношения между разными видами клеток.
Примечание: содержание вироцитов в пределах 10-15% с большой вероятностью указывает на развитие инфекционного мононуклеоза.
При каких заболеваниях характерны атипичные мононуклеары? Это может быть токсоплазмоз, вирус герпесной группы, ВИЧ, онкологические патологии, прочее.
Нередко отмечается превышение нормы содержания после введения вакцины у детей.
-передача «Жить здорово» о симптомах и лечении инфекционного мононуклеоза
Атипичные лимфоциты: норма в анализе крови у взрослых и детей, причины повышения
Противостоять болезням организму помогают антитела. Их выработка происходит в костном мозге. Здесь идёт созревание лимфоцитов, нейтрофилов, базофилов, эозинофилов, моноцитов. Больше всего образуется лимфоцитов – главных борцов иммунной системы, которые занимаются защитой организма.
Наряду с ними существуют клетки с особыми параметрами, функциями. Атипичные лимфоциты – это разновидность иммунных тел. Причиной их появления становятся аллергические реакции, инфекции. Воздействие патогенных организмов меняет их структуру, форму. При нормальном состоянии человека они отсутствуют.
Разного рода заболевания провоцируют их появление.
Атипичные лимфоциты в анализе крови: что это такое и почему появляются? — Диагностика
Многие годы безуспешно боретесь с ГИПЕРТОНИЕЙ?
Глава Института: «Вы будете поражены, насколько просто можно вылечить гипертонию принимая каждый день…
Читать далее »
Атипичные лимфоциты могут возникать при некоторых заболеваниях. Многие считают, что их появление свидетельствует о наличии рака, но это не так. Такие лимфоциты свидетельствуют о наличии аллергии или инфекции.
Лимфоциты — это разновидность лейкоцитов, которые отвечают за защиту органов от патогенных микроорганизмов. Они способствуют уничтожению и выведению из организма бактерий. Под воздействием некоторых из них лимфоциты меняют свои свойства и размер.
Такое состояние не является нормальным и требует дополнительных исследований для выяснения причины проблемы и ее устранения.
Особенности атипичных лимфоцитов
НАШИ ЧИТАТЕЛИ РЕКОМЕНДУЮТ!
Для лечения гипертонии наши читатели успешно используют ReCardio. Видя, такую популярность этого средства мы решили предложить его и вашему вниманию.
Подробнее здесь…
Если в организме начинается патологический процесс, то уровень лимфоцитов возрастает. Такое состояние называют лимфоцитозом. Оно требует дополнительных обследований.
- реактивный. Он развивается, если защитные силы организма ослабевают. Тогда появляется большое количество атипичных клеток, которые обладают неполноценными свойствами;
- постинфекционный. Он возникает, когда человек вылечился от вирусной или инфекционной болезни;
- злокачественный. Это состояние возникает у людей, которые страдают онкологическими заболеваниями. При этом также вырабатывается большое количество атипичных белых кровяных телец.
Атипичные лимфоциты, появившиеся под воздействием антигенов, обретают такие характерные признаки:
- Меняется их размер. В обычном состоянии самые большие лейкоциты — макрофаги достигают в размере не более двенадцати микрометров. Лимфоциты очень редко имеют большие размеры, но под воздействием вирусов они могут вырастать до тридцати микрометров. Именно такими являются атипичные лейкоциты.
- В нормальном состоянии лимфоцит круглой формы. Когда структура клеток меняется, они могут становиться многоугольными с рваными гранями.
- Подвергаются изменениям и ядра лимфоцитов. В анализе крови можно обнаружить, что у атипичного лейкоцита ядро удлиняется и покрывается расщелинами, тогда как в обычном состоянии имеет круглую форму, удлиненную совсем незначительно.
- Меняется и цвет лейкоцитов. Так, процедура анализа крови включает определение окраса клеток крови. Для этого во взятый у пациента биоматериал добавляют гематоксилин и эозин. Это стандартные красители. Во время этой процедуры можно увидеть, что реактивные или атипичные лейкоциты имеют более яркий окрас, чем обычные. Они обретают темно-серый или синий цвет с фиолетовым ядром.
Существует несколько видов реактивных лейкоцитов.
- клетки Дауни. Их открыли в 1923 году. Ученый обнаружил эти клетки у больных, зараженных цитомегаловирусом или вирусом Эпштейна-Барра;
- клетки Ридера или амитотические лимфоциты. Они отличаются от других тем, что их ядро разделено пополам и имеет зазубренные контуры, а сама клетка почкообразной формы;
- клетка Боткина-Клейна-Гумпрехта. Над их описанием работали сразу трое ученых. Подобные лейкоциты обнаруживаются при лимфаденозе. Это мертвые клетки, которые некоторое время находятся в крови. Обнаружить их очень трудно, поэтому их еще называют тенями.
Почему они появляются
Наличие атипичных лимфоцитов чаще всего обнаруживают в крови у ребенка или взрослого при общем анализе крови, когда исследуют ее на уровень эритроцитов, лейкоцитов и тромбоцитов. Но они могут попадать также и в ткани.

Когда человек начинает выздоравливать ситуация улучшается и количество неправильных лимфоцитов уменьшается.
Атипичные лимфоциты могут развиваться под воздействием:
- Лимфолейкоза — это онкологическое заболевание, которое заключается в поражении злокачественными клетками лимфатической ткани.
- Бруцеллеза — это инфекция, которой страдают домашние животные. К человеку она попадает через продукты животного происхождения и поражает нервную и сердечно-сосудистую системы, а также кости и суставы.
- Некоторых стадий сифилиса — венерической инфекции, которая характеризуется поражением кожи, слизистых оболочек, внутренних органов, костей и нервной системы.
- Токсоплазмоза — инфекции, которая обычно протекает бессимптомно и вызывается токсоплазмами. Переносят инфекцию обычно кошки.
- Вирусных инфекций, например, пневмонии, ветрянки, которой чаще всего болеют дети, гепатита и других.
- Некоторых лекарственных препаратов, а также во время лечения иммунными сыворотками животного происхождения.
Поэтому очень важно выявить проблему и ее причину на ранних этапах развития. Это значительно ускорит выздоровление и позволит избежать серьезных последствий для внутренних органов.
Что делать, если обнаружили лимфоциты реактивные
При обнаружении в крови атипичных лейкоцитов необходимо пройти дополнительные исследования, чтобы обнаружить причину возникновения этого явления. Только узнав, что вызвало отклонения, можно подобрать правильную терапию и вылечить пациента.
- Могут использовать самые разнообразные методики и препараты.
- Какой-то определенной терапии нет.
- Лечение зависит от симптоматики:
- если появились отеки, назначают противоаллергические препараты;
- при бактериальных инфекциях не обойтись без антибиотиков;
- желательно укреплять иммунитет. Для этого врач может назначить витаминно-минеральные комплексы, также необходимо вести здоровый образ жизни, правильно питаться, заниматься спортом.
Наличие атипичных клеток в анализе крови свидетельствует о том, что в организм попал вирус, поэтому при наличии такой проблемы необходимо обязательно выяснить причину изменения состава крови и принять соответствующие меры.
Атипичные лимфоциты
Слово атипичные не дарит приятных ассоциаций, ведь атипичными называются измененные клетки организма, вызывающие появление рака. Тем не менее, если вам говорят, что у вас в крови повышены атипичные лимфоциты.
не стоит бить тревогу и писать завещание. В этом случае атипичные значит необычные , то есть имеющие не свойственные лимфоцитам особенности.
С онкологией они не имеют ничего общего и встречаются при совершенно других болезнях.
Что такое атипичные лимфоциты и как они выглядят:
Как известно, при раздражении антигенами, а также во время некоторых заболеваний (вирусные болезни, аллергии) показатели лимфоцитов повышаются. Наряду с этим некоторые из них меняют свои свойства и внешний вид.
Атипичные лимфоциты приобретают следующие особенности
Они становятся крупными. Обычно макрофаги – самые большие лейкоциты, а лимфоциты редко вырастают более чем до 12 мкм. Когда они становятся атипичными, их размер может составлять 30 мкм и более.
Нормальный лимфоцит имеет форму, близкую к округлой. Измененные же формы клеток приобретают неправильную, многоугольную форму, а их границы могут выглядеть рваными .
Ядро обычной клетки округлое или немного вытянутое. У атипичного лимфоцита оно может таким оставаться, однако зачастую бывает удлиненным, с изъеденными контурами, перетяжками или расщелинами. Бывает уменьшенным.
Если мазок крови, в котором изучают показатели лимфоцитов, окрасить стандартными красителями (для этого используют гематоксилин и эозин), то атипичные клеточки будут приобретать более яркую окраску, чем нормальные .
Ядро их фиолетовое, а цитоплазма серая, темно-синяя либо голубая.Если атипичные лимфоциты появились у пациента, зараженного цитомегаловирусом или вирусом Эпштейна-Барра, то их называют клетками Дауни.
Дело в том, что в 1923 году американский врач-гематолог с такой фамилией одним из первых увидел их в микроскоп и описал их свойства.Некоторые лимфоциты с атипичными свойствами также называют клетками Ридера, или амитотическими лимфоцитами.
Их особенность состоит в том, что у них почкообразная форма и ядра с зазубренными контурами или перетяжкой посередине, разделяющей их на дольки.
Также среди атипичных лимфоцитов выделяют клетки Боткина-Клейна-Гумпрехта. Сразу три ученых описали специфические клетки, которые встречаются при лимфаденозах. Собственно, это не живые клетки, а их останки, которые какие-то время циркулируют в крови. За то, что их едва видно, эти лимфоциты еще называют клетками-тенями.
Где находятся атипичные лимфоциты:
Обнаруживают их главным образом в крови, так как именно кровь берут на анализ, чтобы изучить эритроциты, лейкоциты, лимфоциты и прочие важные показатели. Но в тканях их тоже немало.
В организме взрослого человека может быть 6% атипичных лимфоцитов, даже если этот человек полностью здоров. Когда же в связи с болезнью у пациента наблюдаются высокие лимфоциты в крови. то показатель атипичных может подниматься до 7-10% и выше.
Чем обусловлено появление атипичных лимфоцитов?
Стоит больному пойти на поправку, и картина крови тут же, всего за несколько дней, налаживается.
Иногда высокие лимфоциты в крови и появление атипичных форм наблюдаются не только при ОРВИ и аллергиях. но и в более серьезных ситуациях. К появлению их большого количества могут приводить коклюш, сифилис, туберкулез. лимфолейкоз, бруцеллез, токсоплазмоз, сывороточная болезнь.
Что делать, если в крови повышены атипичные лимфоциты?
Вариант только один: лечиться, принимая терапию, прописанную доктором. Это, в зависимости от природы заболевания, могут быть самые разные медикаменты и методики. Кроме того, по согласованию с лечащим врачом можно принимать препарат Трансфер Фактор .
Присутствие атипичных лимфоцитов указывает на то, что иммунная система человека работает в напряженном режиме. Это средство позволяет ей помочь.
Оно создано на основе информационных молекул, извлеченных из коровьего молозива и яичных желтков. Молекулы обучают лимфоциты правильной работе, что ускоряет их образование, созревание и повышает работоспособность.
Регулярный прием препарата помогает быстрее восстановить здоровье и вернуть нормальные показатели крови.
Причины появления атипичных лимфоцитов в крови:
- Лимфолейкоз.
- Вирусная инфекция — инфекционный лимфоцитоз, инфекционный мононуклеоз, инфекционный гепатит, вирусная пневмония. экзантема в детском возрасте, паротит, ветрянка, цитомегаловирусная и эпштейн-барр вирусная инфекция.
- Коклюш .
- Бруцеллез.
- Сифилис (на некоторых стадиях).
- Токсоплазмоз.
- Реакции на лекарства и сывороточная болезнь.